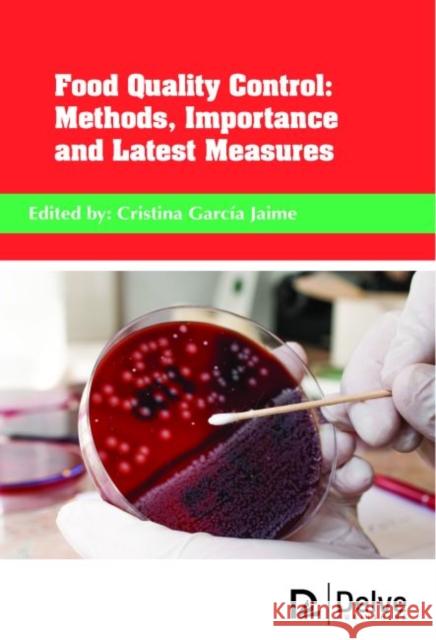
Food Quality Control: Methods, Importance and Latest Measures

topmenu
Garcia, Jaime
Siendo el pastor de una iglesia en Colombia cai en tentacion y cometi adulterio. Cai muy bajo, llegando al extremo de abandonar a mi esposa y mis dos hijas, debido a una adiccion sexual. Esto ocurrio porque, aunque era un pastor, tome decisiones basado en lo que sentia y no en lo que Dios decia. Despues de una sucesion de errores muy serios, destrui mi familia. Los sentimientos de rechazo, culpa y baja autoestima me atormentaban de dia y de noche. Pero le doy gracias al Senor por mi preciosa y fiel esposa Liliana, quien a pesar de mis actos, decidio creerle al Senor y oro, junto a un ejercito